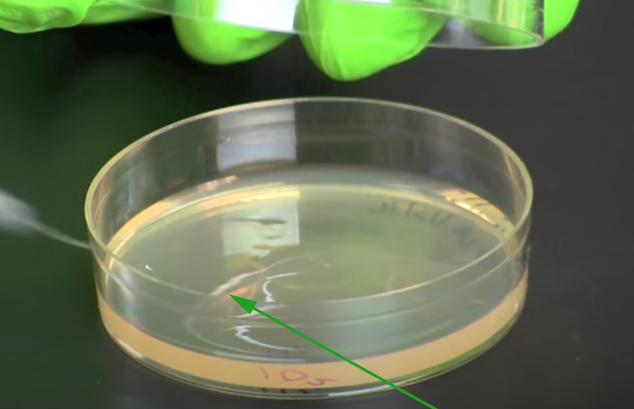

What is the name of this organism?
A) Butterfly Larvae
B) Moth Larvae
C) Spider
D) Eye Of A Beetle

Correct Answer:
D) Eye Of A Beetle
What is the name of this object?
A) Sternochetus
B) Insect Hair
C) Water Droplet From The Ocean
D) Fire From A Cloth

Correct Answer:
A) Sternochetus
What is the name of this object?
A) Nickel Highlighted
B) Breast Tissue In Lactation
C) Chicken Embryo
D) Aluminum

Correct Answer:
B) Breast Tissue In Lactation
What is the name of this organism?
A) Bee Stinger
B) Tick Leg
C) Mold
D) Spider Pedipalp

Correct Answer:
C) Mold
What is the name of this?
A) Grass
B) Fruit Fly Ovary
C) Wheat
D) Insect Hair

Correct Answer:
B) Fruit Fly Ovary
What is the name of this organism?
A) Tarantula Fang
B) Butterfly Larvae
C) Worm
D) Eyelash Mite

Correct Answer:
A) Tarantula Fang
What is the name of this organism?
A) Dandelion Pollen
B) Land Worm
C) Spider Pedipalp
D) Insect Hairs

Correct Answer:
A) Dandelion Pollen
What is the name of this object?
A) Bee Haris
B) Wheat
C) Silk Stands
D) Dry Grass

Correct Answer:
A) Bee Haris
What is the name of this organism?
A) Human Hair
B) Pollen Grain
C) Wool Fibers
D) Red And Green Algae

Correct Answer:
D) Red And Green Algae
What is the name of this organism?
A) Liver Cell
B) DNA
C) Fern Sorus
D) Plant Leaf

Correct Answer:
C) Fern Sorus
What is the name of the instrument on the right?
A) Inoculation Pin
B) Inoculation Loop
C) Inoculation Tool
D) Inoculation Needle

Correct Answer:
B) Inoculation Loop
What is the name of this object being shown by the arrow?
A) Base
B) Valve
C) Arm
D) Flame

Correct Answer:
B) Valve
The coolest flame is:
A) Yellow And Oranage
B) Purple
C) Red
D) Blue

Correct Answer:
A) Yellow And Oranage
What is this particular process known as?
A) Optimization
B) Sterilization
C) Mobilization
D) Catherization

Correct Answer:
B) Sterilization
When this step is complete, you should immediately set down your inoculation tool.
A) No
B) I’m Not Sure
C) Yes
D) Sometimes

Correct Answer:
A) No
What is being spread out over this petri dish?
A) Viral Culture
B) Water
C) Skin Cells
D) Bacteria Culture
Correct Answer:
D) Bacteria Culture
What is the step right before replacing the lid?
A) Turn Off The Bunsen Burner
B) Flame The Mouth Of The Tube
C) Nothing, Just Replace The Lid
D) Place More Bacteria In The Tube

Correct Answer:
B) Flame The Mouth Of The Tube
How many times is this inoculation tool dipped into this test tube here?
A) 4
B) 2
C) 3
D) 1

Correct Answer:
C) 3
What step occurs here?
A) Allow The Loop To Cool
B) Do Not Allow The Loop To Cool
C) Sterilize The Loop One More Time
D) None Of These

Correct Answer:
A) Allow The Loop To Cool
Before transferring the bacteria from the petri dish into the test tube, it is important to place the inoculation tool under the flame one more time.
A) No
B) Yes
C) On Occasion
D) I Don’t Know

Correct Answer:
A) No


